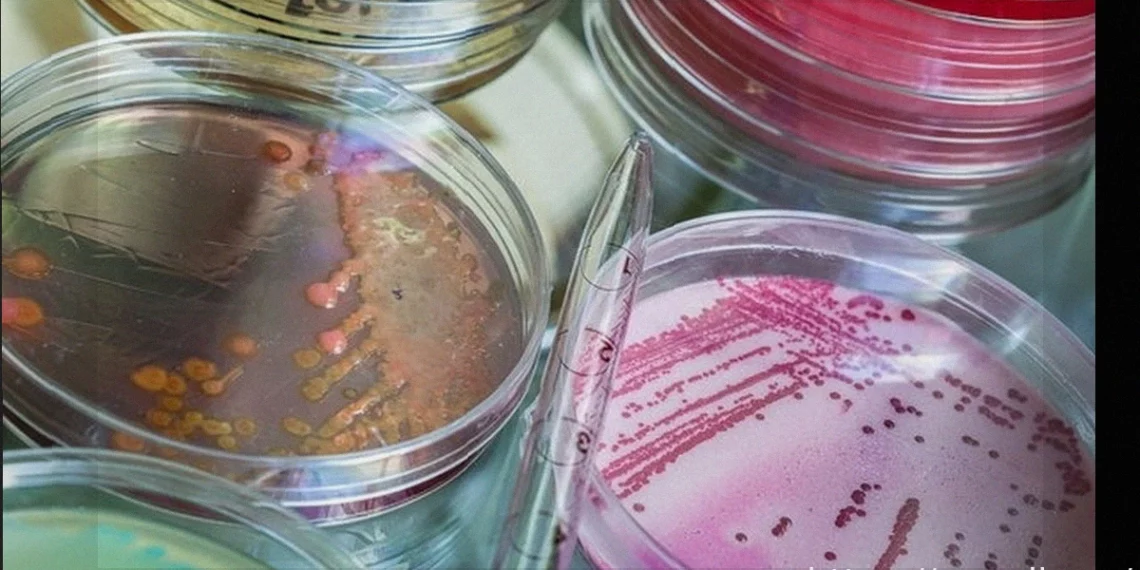

Staphylococcus aureus, или S. aureus, — это бактерия, которая обычно присутствует на коже и слизистых оболочках человека, преимущественно во рту и носу, не причиняя вреда организму. Однако, когда иммунная система ослаблена или имеется рана, эта бактерия может начать активно размножаться и попасть в кровоток, что приводит к развитию сепсиса – тяжелого генерализованного инфекционного и воспалительного процесса.
Инфекции, вызванные S. aureus, могут варьироваться от относительно простых, например, фолликулита, до более серьезных состояний, таких как эндокардит, характеризующийся присутствием бактерий в сердце. Соответственно, симптомы могут быть самыми разнообразными: от покраснения кожи до мышечных болей и кровотечений.
Лечение инфекции, вызванной S. aureus, должно проводиться под наблюдением врача с учетом профиля чувствительности бактерии к антибиотикам. Как правило, назначаются антибиотики, такие как метициллин или оксациллин.

Основные симптомы
К основным симптомам инфекции, вызванной S. aureus, относятся:
- Боль в месте поражения;
- Отек и покраснение кожи;
- Появление абсцессов и волдырей;
- Высокая температура, если бактерия попадает в кровоток;
- В некоторых случаях мышечные боли;
- Головная боль;
- Одышка, если инфекция достигает легких;
- Тошнота и рвота, при поражении желудочно-кишечного тракта;
- Боль в животе и диарея, если бактерия попадает в кишечник.
В зависимости от интенсивности симптомов инфекции, пациенту может потребоваться госпитализация, а иногда и изоляция, до полного излечения.
Как происходит передача
Бактерия Staphylococcus aureus может естественным образом находиться в организме, в основном на коже, во рту и носу, не вызывая никаких признаков или симптомов. Однако в некоторых случаях она может проникнуть в организм через раны и вызвать признаки и симптомы инфекции, особенно если ей удается попасть в кровоток и начать размножаться.
Заболевания, вызываемые Staphylococcus aureus
К основным заболеваниям, которые может вызывать Staphylococcus aureus, относятся:
- Фолликулит: характеризуется появлением небольших гнойных волдырей и покраснения кожи, вызванных размножением бактерий в области волосяных фолликулов.
- Инфекционный целлюлит (флегмона): в этом случае S. aureus проникает в более глубокие слои кожи, вызывая боль, отек и сильное покраснение.
- Септицемия (сепсис) или септический шок: представляет собой генерализованную инфекцию, при которой бактерия присутствует в кровотоке, способная поражать различные органы.
- Эндокардит: заболевание, поражающее сердечные клапаны из-за присутствия бактерии в сердце.
- Остеомиелит: инфекция костной ткани, вызванная бактериями, которая может возникнуть при прямом заражении кости через глубокий порез, перелом или установку протеза, например.
- Пневмония: респираторное заболевание, приводящее к затрудненному дыханию, которое может быть вызвано бактериальным поражением легких.
- Синдром токсического шока или синдром ошпаренной кожи: кожное заболевание, вызванное продукцией токсинов Staphylococcus aureus, приводящее к отслоению кожи.
- Пищевое отравление: может произойти из-за употребления зараженных продуктов, особенно колбасных изделий, содержащих токсины, производимые S. aureus.
Люди с ослабленной иммунной системой из-за онкологических, аутоиммунных или инфекционных заболеваний, перенесшие ожоги или травмы, а также прошедшие хирургические вмешательства, имеют повышенный риск развития инфекций, вызванных Staphylococcus aureus.
Поэтому важно тщательно мыть руки и соблюдать необходимые меры предосторожности в больничных условиях, чтобы избежать заражения этой бактерией, а также употреблять продукты, укрепляющие иммунную систему.
Как проводится диагностика
Диагностика основана на выделении бактерии, которое проводится в микробиологической лаборатории из биологического образца. Образец запрашивается врачом в соответствии с симптомами пациента и может быть мочой, кровью, слюной или выделениями из раны.
После выделения бактерии проводится антибиотикограмма для определения профиля чувствительности микроорганизма и выбора наиболее эффективного антибиотика для лечения инфекции.
Лечение инфекции, вызванной S. aureus
Лечение инфекции, вызванной S. aureus, обычно определяется врачом в соответствии с типом инфекции и симптомами пациента. Кроме того, необходимо учитывать наличие других сопутствующих инфекций, при этом врач оценивает, какая инфекция представляет наибольший риск для пациента и требует более быстрого лечения.
На основании результатов антибиотикограммы врач может назначить наиболее эффективный антибиотик против бактерии. Лечение обычно проводится метициллином или оксациллином в течение 7-10 дней.
Метициллинрезистентный Staphylococcus aureus (MRSA)
Метициллинрезистентный Staphylococcus aureus, также известный как MRSA, очень распространен, особенно в больницах, что делает эту бактерию одной из основных причин внутрибольничных инфекций.
Метициллин – это антибиотик, разработанный для борьбы с бактериями, продуцирующими бета-лактамазы – ферменты, вырабатываемые некоторыми бактериями, включая S. aureus, как защитный механизм против определенного класса антибиотиков. Однако некоторые штаммы Staphylococcus aureus, особенно те, которые встречаются в больницах, развили устойчивость к метициллину, не реагируя на лечение этим антибиотиком.
Таким образом, для лечения инфекций, вызванных MRSA, обычно используются гликопептиды, такие как ванкомицин, тейкопланин или линезолид, в течение 7-10 дней или в соответствии с указаниями врача.